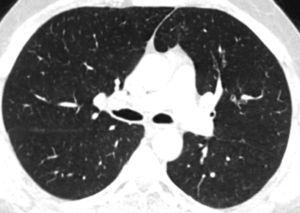

Dear Editor,
Hypereosinophilia (HE) is defined as peripheral blood eosinophils >1.5 eosinophils × 109/L blood on 2 examinations and/or tissue HE defined by the following: (1) the percentage of eosinophils in the bone marrow section exceeds 20% of all nucleated cells and/or (2) the pathologist is of the opinion that tissue infiltration by eosinophils is extensive and/or (3) marked deposition of eosinophil granule proteins is found (in the absence or presence of major tissue infiltration by eosinophils). Hypereosinophilic syndrome (HES) is defined by the following: (1) criteria for peripheral blood hypereosiniphilia (HE) fulfilled and (2) organ damage and/or dysfunction attributable to tissue HE and (3) exclusion of other disorders or conditions as major reason for organ damage. HES subtypes have been defined; these include (1) idiopathic HES, (2) primary (neoplastic) HES, (3) secondary (reactive) HES.1 We here report a case of idiopathic hypereosinophilic syndrome successfully treated with imatinib.
A forty-six-year-old male patient was admitted to our clinic with complaints of itching, cough, shortness of breath, and stomach pain. The symptoms had increased over the last six months. He had a history of chronic smoking (30 pack-years). There was no history of any drug use. Admission blood pressure: 110/80 mmHg; respiratory rate 20/min; pulse 95/min; saturation in room air was found to be 95%. Breath sounds were bilaterally decreased. Widely excoriated itchy lesions were present. There was tenderness in the epigastric region. Blood eosinophil rate was 55.4% (9880/mm3). Parasite stool examination and serologic tests were negative. A mild obstructive pattern was present in the pulmonary function test. However, the patient did not benefit from treatment with high doses of inhaled corticosteroids/β2 agonists. Laboratory tests showed no significant alterations except increased vitamin B12: 1081 pg/ml (reference range: 111–663 pg/ml) and total IgE: 194 IU/ml (reference range: <100 IU/ml) autoimmunity work-up was negative. Troponin T and echocardiography were normal.
Centrilobular ground-glass nodules were found to be more prominent in the upper lobes of the lungs in thorax computed tomography (CT) (Figure 1a). Abdominal CT and ultrasonography were found to be normal. Endoscopic biopsy for stomach pain was reported as eosinophilic gastritis. Eosinophilic infiltration was observed on transbronchial lung biopsy. Numerous eosinophilic granulocytes (40%) were observed in bone marrow biopsy without increased blast cells. A prominent mast cell population was not observed. There was no malignant infiltration. FIPLI-PDGFRα mutation, JAK-2 mutation and Philadelphia chromosome were also found to be negative.
Figure 1a. Axial CT image at lung window setting showing centrilobular ground-glass nodules (circles).
In our case, differential diagnosis was performed for primary (hematopoietic neoplasms with HE) and secondary HES, (helminth infections, allergic reactions, atopic diseases, drug reactions (allergic or toxic), Hodgkin disease, B- or T-cell lymphoma/leukemia, Langerhans cell histiocytosis, indolent systemic mastocytosis, solid tumors/malignancy, allergic bronchopulmonary aspergillosis, chronic inflammatory disorders, autoimmune diseases and lymphoid variant of HES), organ-restricted conditions accompanied by HE (eosinophilic gastrointestinal disorders, eosinophilic pneumonia, dermatologic diseases, etc.) and specific syndromes accompanied by HE (Gleich syndrome, Churg-Strauss syndrome, eosinophilia myalgia syndrome, Hyper-IgE syndrome).1, 2, 3, 4, 5, 6 The patient was diagnosed with idiopatic HES after exclusion of all primary and secondary causes and exclusion of other conditions and syndromes. The patient was started on imatinib mesylate therapy with 400 mg/day because he did not respond to corticosteroids (CS) and hydroxyurea therapy. The treatment was reduced to a 100 mg in the third month of treatment due to normalization of eosinophil levels and disappearance of all complaints. The ground-glass nodules disappeared after 1 year of imatinib treatment (Figure 1b).
Figure 1b. Axial CT image at the same level as in Fig. 1a showing disappearance of ground-glass nodules.
CS have been used for decades in the treatment of HES, with the exception of PDGFR-α associated HES. A number of cytotoxic therapies have been used for the management of corticosteroid-refractory HES. Of these, hydroxyurea has been the most extensively studied. However, the utility of hydroxyurea monotherapy is limited in the treatment of HES. Imatinib mesylate is a tyrosine kinase inhibitor with activity against several receptor tyrosine kinases, including the fusion kinase FIP1L1/PDGFR-α, which is responsible for PDGFR-α-associated HES. The utility of imatinib therapy in hypereosinophilic patients without a demonstrable FIP1L1/PDGFR-α mutation remains controversial, although some patients have demonstrated a response. In such cases, imatinib could be prescribed as second-line treatment, after demonstration of complete resistance to CS.3, 5, 6, 7
In conclusion, idiopatic HES is an exclusion diagnosis. Therefore, a wide differential diagnosis is required. Imatinib should be reserved for corticosteroid nonresponders cases with idiopatic HES.
Conflicts of interestThe authors have no conflicts of interest to declare.
Corresponding author. insu2004@yahoo.com